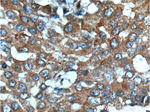
KIAA0090 Antibody in Immunohistochemistry (Paraffin) (IHC (P))

Search
Proteintech
KIAA0090 Polyclonal Antibody
{{$productOrderCtrl.translations['antibody.pdp.commerceCard.promotion.promotions']}}
{{$productOrderCtrl.translations['antibody.pdp.commerceCard.promotion.viewpromo']}}
{{$productOrderCtrl.translations['antibody.pdp.commerceCard.promotion.promocode']}}: {{promo.promoCode}} {{promo.promoTitle}} {{promo.promoDescription}}. {{$productOrderCtrl.translations['antibody.pdp.commerceCard.promotion.learnmore']}}
产品信息
26017-1-AP
种属反应
宿主/亚型
分类
类型
抗原
偶联物
形式
浓度
规格
纯化类型
保存液
内含物
保存条件
运输条件
产品详细信息
Immunogen sequence: KVVLWSREE SLAEVVCLEM VDLPLTGAQA ELEGEFGKKA DGLLGMFLKR LSSQLILLQA WTSHLWKMFY DARKPRSQIK NEINIDTLAR DEFNLQKMMV MVTASGKLFG IESSSGTILW KQYLPNVKPD SSFKLMVQRT TAHFPHPPQC TLLVKDKESG MSSLYVFNPI FGKWSQVAPP VLKRPILQSL LLPVMDQDYA KVLLLIDDEY KVTAFPATRN VLRQLHELAP SIFFYLVDAE QGRLCGYRLR KDLTTELSWE LTIPPEVQRI VKVKGKRSSE HVHSQGRVMG DRSVLYKSLN PNLLAVVTES TDAHHERTFI GIFLIDGVTG RIIHSSVQKK AKGPVHIVHS E (439-788 aa encoded by BC034589)
靶标信息
This gene encodes a single-pass type I transmembrane protein, which is a subunit of the endoplasmic reticulum membrane protein complex (EMC). Multiple alternatively spliced transcript variants encoding different isoforms have been found for this gene.
仅用于科研。不用于诊断过程。未经明确授权不得转售。
生物信息学
蛋白别名: ER membrane protein complex subunit 1; KIAA0090; RP1-43E13.1; unnamed protein product
基因别名: CAVIPMR; EMC1; KIAA0090; PSEC0263
UniProt ID: (Human) Q8N766
Entrez Gene ID: (Human) 23065